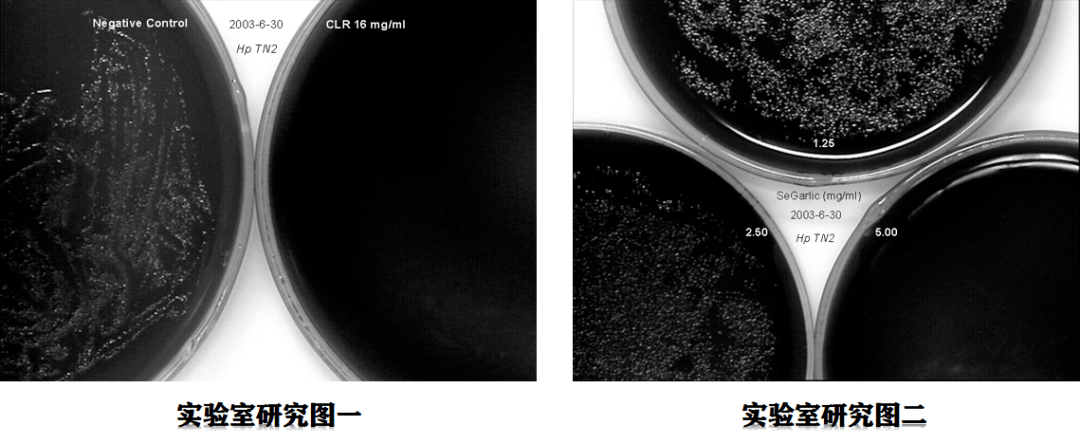

我县开展补硒宣传活动(全民补硒视频宣传)

1科学补硒工程的背景
据世界卫生组织披露,目前全球有20亿人口缺硒,而在中国的众多人口中72%是长期生活在缺硒或贫硒环境中。这些地区的人口肿瘤、肝病、心血管疾病等发病率很高。研究表明,低硒或缺硒会导致心脑血管病、高血压综合症、肝病、糖尿病、胃肠道病、哮喘、癌症等四十余种病高发。硒对癌症、糖尿病、哮喘、高血脂病、动脉硬化、皮肤不良、白内障、肾脏病、心脏病、肝病、风湿病、过敏性体质、关节炎、胃溃疡、肥胖、高血压等都具有很好的防治效果。
国外一位致力于微量元素研究的学者说过这样一段话:对于人类来说,在过去的时间里,最大的悲哀不是缺硒本身,而是我们没有意识到硒对人类健康的重要。难道我们还要把这个遗憾带入21世纪吗?
我国营养学会荣誉理事、微量元素与健康学会名誉会长、著名营养学家于若木教授多次指出:“硒具有抗癌、防衰老和保护人体免疫功能的作用。人体缺硒关系到亿万人民健康的大事,我们应当像补碘那样抓好补硒工作。”
我国许多健康专家、硒研究专家及国家院士都提出补硒的重要性、紧迫性,目前当务之急要做好两件大事:
一、各种舆论媒体应当向居民普及宣传有关硒与人体健康的科普知识,使居民提高如何科学补硒的认知;
二、着手开发与生产符合人类补硒的高安全、高技术含量的、最佳效果的硒类产品,让全社会缺硒的广大民众获得健康。
2005年1月18日在人民大会堂召开的“防病治病、定量补硒”全国工作会议中,来自中国农科院中国科技协会的全国顶级权威在人民大会堂大声疾呼:“科学补硒,刻不容缓”。
2科学补硒工程的起因
在国家提倡“科学补硒,刻不容缓”的号召下,老百姓也逐渐开始重视,但因环境等因素导致我们无法通过饮食正常补硒,只能另觅它法;既而,商家及老百姓都把目光集中到了补硒产品上。目前市售的富硒产品琳琅满目,花样繁多,然而某些硒结构物质是有毒的,服少了不起作用,服多了就会中毒;哪些硒是好的?哪些是不好的?补硒的量是多少才不会中毒?又补多少才会干预治疗各种疾病……等问题困扰着老百姓。在此种情况下,就要求人们补硒要科学,科学补硒才健康。因而,在国家要求和人们如何选硒的大小环境驱使下,我们开展了“科学补硒工程”活动,要运用科学的方法逐渐带领老百姓走出补硒“盲区”,共同探寻硒的绿色健康之路:“科学补硒,刻不容缓”。
3科学补硒工程的概念
即是响应国家号召,如老百姓所愿,运用科学的硒理论知识,以科普宣传教育为主要手段,以结合硒的实际应用效果为现身教育的方法,以集合各地科普宣传志愿者的力量,在当地政府的大力支持下,为老百姓宣讲硒知识的一种纯公益性的科普宣传教育活动。本活动不带有任何牟利、欺骗色彩,是在政府的指导下,由自愿公益事业的志愿者形成的宣传队伍,科学的、严谨的、务实的服务社会。
4科学补硒工程的实施
为了“科学补硒工程”的全面推广与实施,在全国范围内以县、区为单位,设立“科学补硒工程”推广及补硒科普宣传办公室,既称之“科学补硒工程”办公室。宣传推广及实施方案遵照“科学补硒工程”推广中心(公司)制定的标准来规范实施。其主要职责是负责当地区域内科学补硒科普教育宣传工作,组织安排科学补硒科普教育(志愿者)展开宣传;宣传过程中,严格要求、规范实施、科学引导。
5科学补硒工程的框架

6科学补硒工程的目的
“科学补硒工程”是在当今因环境、环境污染及饮食习惯等因素导致的人体缺硒,从而引发一系列疾病甚至于癌症的形势下,采取的势在必行的重要举措。“科学补硒工程办公室”在全国范围内的设立,一方面可以为广大民众抵抗疾病的侵袭提供最有力的保障,支持和引导民众用正确的方式维护自己和家人的健康;另一方面,从长远的角度来看,人民生活越来越好,越来越多的人都在关注健康,“科学补硒工程”正是以最权威的方式引导大家如何正确有效的科学补硒,解决我国缺硒民众的健康;实现贡献社会,造福民众这一宏伟目标。
7如何区分硒产品的成分


补硒就选第三代硒——甲基源硒

亚硒酸钠中毒的肝病理图片
第三代纯植物甲基源硒与第一、二代硒的比较

植物甲基源硒安全性显著高于硒酵母

植物甲基源硒效果显著高于第一第二代硒
第三代纯植物甲基源硒与第一、二代硒的比较
A-对照;B-MNNG group;C-低剂量亚硒酸钠 (75ugSe/kgDW);D- 高剂量亚硒酸钠组(150ugSe/kgDW);E-植物甲基源硒(150ugSe/kgDW);F - Se-Bio-B (150ugSe/kgDW);G-植物甲基源硒(300ugSe/kgDW) ;H- Se-Bio-RK (300ugSe/kgDW) ;I- Se-Bio-GK (300ugSe/kgDW)
第三代纯植物甲基源硒清除致癌因子

继续阅读
- 暂无推荐
